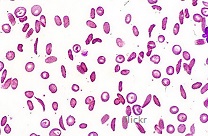

- Summary list for topic 3.1 Genes
- Mindmaps
- Exam style question about genes
- Model answer
- Exam style question on genes.
- Model answer
- 3.1 Genes 1/1
- 3.1 Genes (2) 1/1
Genes provide the instructions to build proteins and more besides. The human genome has been decoded by the human genome project and now biologists can search databases to find the location of specific genes. Our understanding of how gene mutations can lead to genetic diseases like sickle cell disease illustrates how genes control our features. The ability to sequence whole genomes allows us to compare the genes in different species and learn more about how they operate.These slides summarise the essential understanding and skills in this topic.
They contain short explanations in text and images - good revision for all students.
Read the slides and look up any words or details you find difficult to understand.
Summary list for topic 3.1 Genes
- Definition of a gene is, "a heritable factor that consists of a length of DNA and influences a specific charact
eristic." - A gene locus is, "the specific position of a gene on a chromosome."
- Alleles are, "The various specific forms of a gene which differ from each other by one or only a few bases".
- New alleles are formed by mutation.
- A genome is, "the whole of the genetic information of an organism."
- The entire base sequence of human genes was sequenced in the Human Genome Project.
- The Genbank® database can be used to search for DNA base sequences.
Skills & applications
- Application to explain: The causes of sickle cell anemia, including a base substitution mutation, subsequent change to the mRNA transcribed from it and a change to the sequence of amino acids in a polypeptide of hemoglobin.
- Recall of one specific base substitution that causes glutamic acid to be substituted by valine as the sixth amino acid in the hemoglobin polypeptide is required. (Deletions, insertions and frame shift mutations are not needed).
- Application: Comparison of the number of genes in humans with other species.
At least one plant and one bacterium should be included in the comparison and at least one species with more genes and one with fewer genes than a human.
(note: "genome size" is total amount of DNA, not the number of genes in a species). - Skill: Use of a database to determine differences in the base sequence of a gene in two species.
Mindmaps
These diagram summaries cover the main details of topic 3.1 Genes.
Study them and draw your own list or concept map, from memory if you can.
Exam style question about genes
The skill of interpreting DNA sequences alignments is important in this topic.
Answer the question below on a piece of paper, then check your answer with the model answer.
Compare and contrast DNA base sequences shown of three blood group alleles below [3]
The data comes from a sequence alignment search using the Anagène DNA database.
.jpg)
....................................................................................... ............................................................................
....................................................................................... ............................................................................
....................................................................................... ............................................................................
....................................................................................... ............................................................................
Click the + icon to see a model answer.
A quiz containing multiple choice questions covering the understanding and skills outlined in the image above.
START QUIZ!
Drag and drop activities
Test your ability to construct biological explanations using the drag and drop questions below.
Sickle cell anaemia is an example of a mutation that is given in the syllabus content and should be known. This mutation affects the shape of red blood cells, shown in the image of sickle cell trait red blood cells.
Drag and drop the correct word or phrase into the gap to outline the sickle cell anaemia mutation.
single base amino acid sequence gene structure codon anticodon glutamate shape mutant GTG CAC tRNA Distractor base sequence
A mutation is a change in the of a .
Sickle cell anaemia is a form of the human haemoglobin gene. The mutant form of haemoglobin that causes sickle-cell anaemia is a mutation where the triplet sequence in the haemoglobin DNA has mutated from GAG to .
This mutation transcribes to mRNA as instead of CUC. On translation, the triplet CAC translates into the amino acid instead of valine in the of the haemoglobin protein.
This change affects the tertiary of haemoglobin making it fibrous and less efficient in transporting oxygen and changes the of the red blood cells.
A mutation in DNA will alter the base sequence of mRNA transcribed from the DNA and may effect the amino acid sequence of the protein which is translated from the mRNA.
If you want to review key terminology and have some fun with your revision try this Genes card match game. Can you reach the leader board?
How much of Genes 3.1 have you understood?














